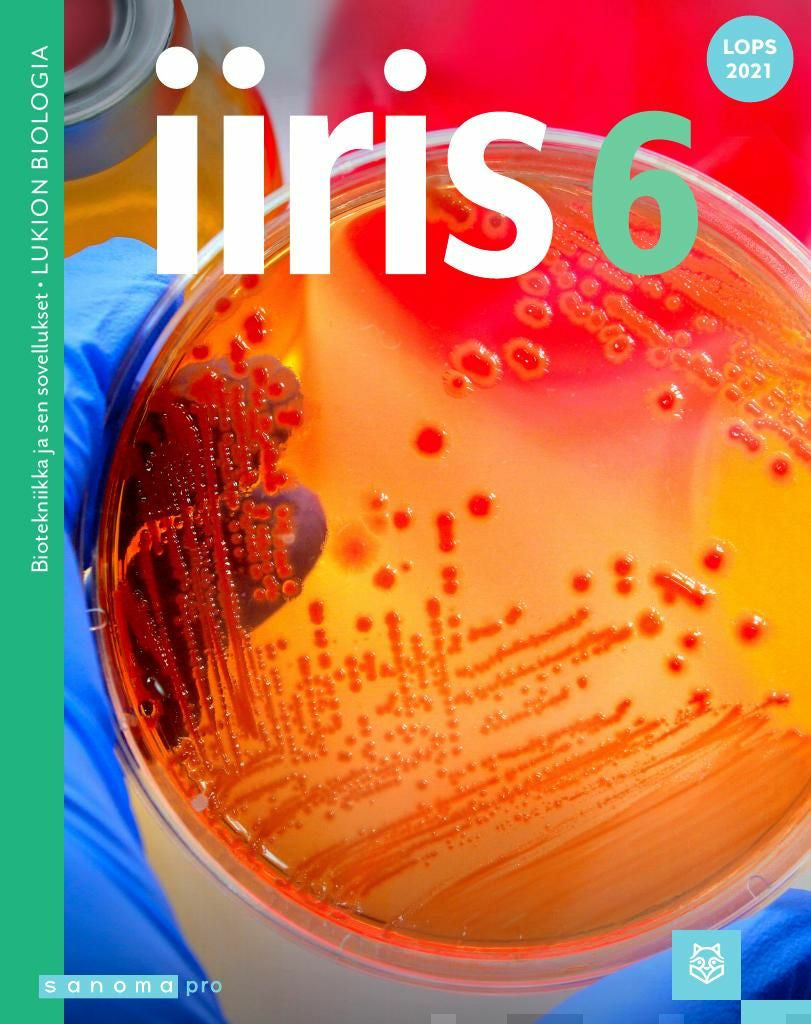

Iiris 6 (LOPS21)
Iiris 6 Biotekniikka ja sen sovellukset on lukion biologian kuudennen moduulin oppimateriaali. Iiris 6 oppimateriaali auttaa opiskelijaa ymmärtämään biologisen tutkimuksen merkityksen sovellusten kehittämisessä niin lääketieteessä, teollisuudessa, elintarviketuotannossa kuin luonnonvarojen kestäv... Lue lisää
Iiris 6 Biotekniikka ja sen sovellukset on lukion biologian kuudennen moduulin oppimateriaali. Iiris 6 oppimateriaali auttaa opiskelijaa ymmärtämään biologisen tutkimuksen merkityksen sovellusten kehittämisessä niin lääketieteessä, teollisuudessa, elintarviketuotannossa kuin luonnonvarojen kestäv... Lue lisää
-
Tuotekuvaus
Iiris 6 Biotekniikka ja sen sovellukset on lukion biologian kuudennen moduulin oppimateriaali. Iiris 6 oppimateriaali auttaa opiskelijaa ymmärtämään biologisen tutkimuksen merkityksen sovellusten kehittämisessä niin lääketieteessä, teollisuudessa, elintarviketuotannossa kuin luonnonvarojen kestävän kehityksen mukaisessa käytössä.
Iiris-sarja avaa biologian ihmeellisen maailman elämyksellisellä tavalla. Isot, pysäyttävät lukujen aloituskuvat herättävät opiskelijoiden mielenkiinnon. Innostusta ylläpitävät oudot, yllättävät ja hauskat nostot biologian maailmasta. Korkeakouluyhteistyö on huomioitu Iiriksessä muun muassa Tutustu tutkijaan -teksteissä, joissa oikeat tutkijat pääsevät kertomaan omasta työstään. Iiris 6 oppikirjasta saa parhaan hyödyn käyttämällä sitä yhdessä digikirjan kanssa. Iiris 6 -digikirja sisältää itsetarkistuvia tehtäviä sekä monipuolisia aineistotehtäviä. Tehtävien vastaukset löytyvät opettajalle pdf-tiedostona, ja ovat opiskelijoille jaettavissa suoraan digikirjassa. -
Tuotetiedot
- Kustantaja / Valmistaja Sanoma Pro
- ISBN 9789526360751
- Tuotekoodi 9789526360751
- Alanimike Biotekniikka ja sen sovellukset
- Kirjoittajat Hanna Buuri; Reetta Kariola; Jari Kolehmainen; Roosa Laitinen; Elisa Mehtälä; Petri Ojala
- Sarja Iiris
- Kieli Suomi
- Thema-luokitus Oppimateriaalit: biologia
- Ilmestymispäivä 31.03.2023
- Vuosi 2023
- Tuoteryhmä Lukiokirjat
- Tuotepääryhmä Oppikirjat
- Tuotelinja Kirjat
- Oppiaine Biologia (Lukiokoulutus)
- Sivumäärä 176
- Kirjastoluokka 56
- Kirjastoluokan kirjain J
- Pituus (mm) 210
- Leveys (mm) 264
- Korkeus (mm) 9
- Paino (g) 470
- Tuotemuoto Pehmeäkantinen
- ALV 13,5%
Tämä tuote kuuluu tuoteryhmiin
Tuotearvostelut Suomalainen.comissa
Tutustu tuotearvostelujen käytäntöihin ja ehtoihin ennen kuin jätät arvostelun.
Suomalainen.com -verkkokaupassa on mahdollista jättää tuotearvosteluja siellä myynnissä olevista tuotteista. Tuotearvosteluja voivat jättää sekä tuotetta Suomalaisesta Kirjakaupasta ostaneet asiakkaat että muut sivuston käyttäjät. Arvostelijan nimimerkin jälkeinen teksti kertoo, onko kyseessä vahvistettu ostaja vai muu asiakas/sivuston käyttäjä.
-
Vahvistettu ostaja - Kyseinen arvostelu on jätetty käyttämällä tuotteen ostajalle lähetettyä sähköpostilinkkiä. Kyseessä on siis vahvistettu ostaja eli arvostelun jättänyt henkilö on ostanut todennetusti kyseisen tuotteen.
-
Vahvistettu suosittelija - Kyseinen arvostelu on jätetty suomalainen.com -verkkosivustolla. Arvostelijan sähköpostiosoite on vahvistettu, jotta on voitu varmistua siitä, että arvostelun on jättänyt oikea henkilö. Suomalainen.com ei kuitenkaan ole vahvistanut, että kyseinen henkilö on ostanut tuotteen.
- Ei tekstiä nimimerkin jälkeen - Kyseinen arvostelu on jätetty suomalainen.com -verkkosivustolla, mutta arvostelun jättäjän sähköpostiosoitetta ei ole vahvistettu.
Tuotearvostelussa pakollisia tietoja ovat tuotteen pistemäärä (tähdet), otsikko sekä arvosteluteksti. Jos jätät arvostelun sinulle lähetetyn sähköpostilinkin kautta, arvostelu julkaistaan käyttämällä etunimeäsi sekä sukunimen ensimmäistä kirjainta.
Jos jätät arvostelun sivustollamme, voit käyttää arvostelussa myös nimimerkkiä. Arvostelun jättämisen yhteydessä sinulta kysytään sähköpostiosoitetta, jonka avulla vahvistamme, että arvostelun on lähettänyt oikea henkilö, eikä esimerkiksi robotti. Tuotearvostelujen palveluntarjoajana toimii Yotpo. Katso Yotpon tietosuojaseloste.
Arvostelut julkaistaan tuotteen kohdalla automaattisesti ja ne tulevat esiin viiveellä. Suomalainen.com pidättää kuitenkin oikeuden poistaa kommentit, jotka sisältävät epäasiallista, herjaavaa tai halventavaa kieltä, vihapuhetta tai ovat muuten hyvän tavan vastaisia, tai joissa markkinoidaan muiden toimijoiden sivustoja tai tuotteita.
Jättämällä arvostelun annat Suomalaiselle Kirjakaupalle oikeuden käyttää kyseisiä arvosteluja omassa markkinoinnissaan (sekä painettu että digitaalinen) ilman erillistä korvausta. Arvosteluja käytetään myös analysointiin ja markkinoinnin kehittämiseen.
Tuotearvostelun jättäneiden kesken arvotaan säännöllisin väliajoin tuotepalkintoja. Tutustu arvonnan sääntöihin täällä.
Mikäli haluat poistaa jättämäsi tuotearvostelun verkkokaupastamme, pyyntö tästä tulee ohjata asiakaspalveluumme: asiakaspalvelu@suomalainen.com.
Tuotearvostelut eivät ole tarkoitettu asiakasreklamaatioiden tai tilauskyselyjen tekemiseen. Reklamaatiotapauksissa pyydämme ottamaan yhteyttä asiakaspalveluumme: asiakaspalvelu@suomalainen.com.
Jättämällä arvostelun suomalainen.com -verkkokauppaan hyväksyt yllämainitut käytännöt ja ehdot.
Lue lisää tuotearvosteluista.